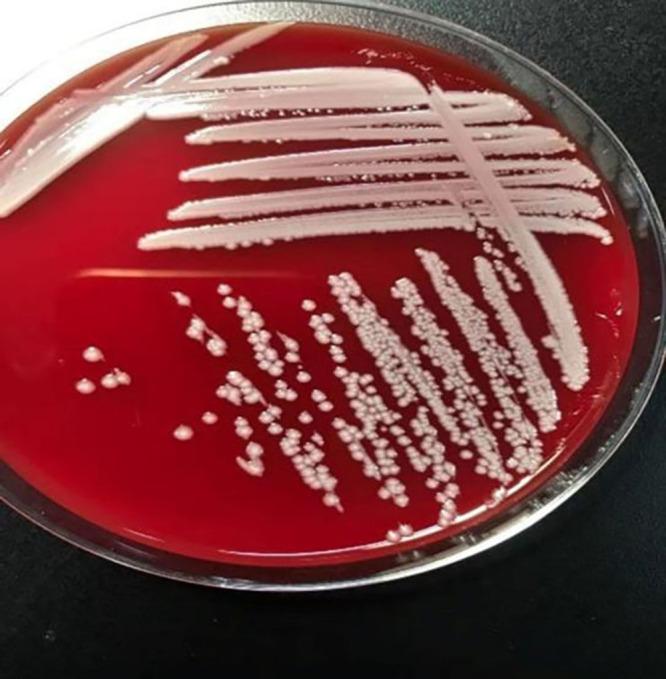
https://cdn.ncbi.nlm.nih.gov/pmc/blobs/a5a5/9725920/18f7c3bbef95/IDR-15-7043-g0002.jpg

一名非囊性纤维化患者多发伤后感染所致脓毒症:来自中国东南部的病例报告
Sepsis Due to Infection After Multiple Trauma in a Non-Cystic Fibrosis Patient: A Case Report from Southeast China.
作者信息
Ma Zhiyi, Zou Xin, Lin Jinhao, Zhang Chunchun, Xiao Shuhua
机构信息
Department of Pulmonary and Critical Care Medicine, Longyan First Affiliated Hospital of Fujian Medical University, Longyan, People's Republic of China.
Department of Pulmonary and Critical Care Medicine, Longyan People's Hospital, Longyan, People's Republic of China.
出版信息
Infect Drug Resist. 2022 Dec 2;15:7043-7052. doi: 10.2147/IDR.S388520. eCollection 2022.
() infection is of great concern as these gram-negative bacillus species are multidrug-resistant and usually isolated from the patients' respiratory tract suffering from cystic fibrosis (CF). A few cases of infection have also been reported in non-CF patients due to its rare pathogenic nature with unclear and overlapping clinical, biochemical, and microbiological characteristics with other species. Here, we report an unusual case of a 46-year-old non-CF female, who presented with multiple pelvic fractures, acute traumatic brain injury, multiple rib fractures, and multiple burns (18% of the total body surface area, II°) by the collapse of a brick kiln, suffered from sepsis due to wound infection. Pandoraea species were isolated both from her blood and wound secretion. Antibiotic susceptibility testing indicated susceptibility to imipenem, tetracyclines, sulfamethoxazole, and ampicillin/sulbactam but resistance to meropenem, quinolones, aminoglycosides, and other beta-lactams. 16S ribosomal RNA (rRNA) PCR assays and matrix-assisted laser desorption/ionization time-of-flight mass spectrometry (MALDI-TOF MS) were used to confirm the bacteria as . After effective anti-infection of intravenous antibiotics (imipenem 1.0 Q8H with tigecycline 50 mg Q12H for 14 days), wound care, and other comprehensive treatment for two months, the patient improved and was discharged from the hospital eventually. After reviewing the literature, we observed that the susceptibility results of Pandoraea species were often multidrug-resistant and had a unique pattern of being resistant to meropenem but sensitive to imipenem. Biofilm formation, carbapenemase production, and unique gene procession differed from the environmental isolates could help explain its resistance. This case report highlights the potential virulence of as a pathogen in patients with no underlying disease. Although they are often multi-resistant, imipenem can be a preferred treatment for Pandoraea species in the earliest identification steps.
()感染备受关注,因为这些革兰氏阴性杆菌具有多重耐药性,通常从患有囊性纤维化(CF)的患者呼吸道中分离得到。由于其致病性罕见,临床、生化和微生物学特征与其他菌种不明确且重叠,在非CF患者中也有少数感染病例报道。在此,我们报告一例不同寻常的病例,一名46岁非CF女性,因砖窑倒塌导致多处骨盆骨折、急性创伤性脑损伤、多根肋骨骨折和多处烧伤(占体表面积的18%,二度),因伤口感染而发生败血症。从她的血液和伤口分泌物中均分离出潘多拉菌属。药敏试验表明对亚胺培南、四环素、磺胺甲恶唑和氨苄西林/舒巴坦敏感,但对美罗培南、喹诺酮类、氨基糖苷类和其他β-内酰胺类耐药。采用16S核糖体RNA(rRNA)聚合酶链反应(PCR)检测和基质辅助激光解吸/电离飞行时间质谱(MALDI-TOF MS)来确认该细菌为 。经过静脉使用抗生素(亚胺培南1.0克每8小时一次,替加环素50毫克每12小时一次,共14天)进行有效抗感染、伤口护理及其他综合治疗两个月后,患者病情好转并最终出院。查阅文献后,我们发现潘多拉菌属的药敏结果通常为多重耐药,且具有对美罗培南耐药但对亚胺培南敏感的独特模式。生物膜形成、碳青霉烯酶产生以及与环境分离株不同的独特基因进程可能有助于解释其耐药性。本病例报告强调了 在无基础疾病患者中作为病原体的潜在毒力。尽管它们通常具有多重耐药性,但在最早的识别阶段,亚胺培南可作为治疗潘多拉菌属的首选药物。